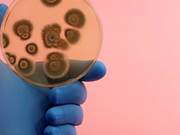

Flow Solver Tutorial
...--introduction--> The purpose of this example is to give an overview of how to set up and use the single-phase mimetic pressure solver to solve the single-phase pressure equation for a flow driven by Dirichlet and Neumann boundary conditions. Our geological model will be simple a Cartesian grid with...